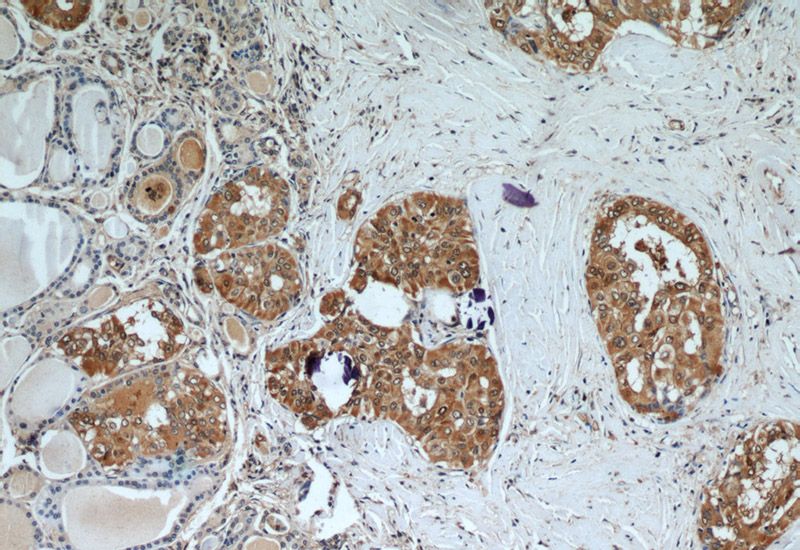
Immunohistochemical of paraffin-embedded human thyroid cancer using Catalog No:110840(Galectin 3 antibody) at dilution of 1:50 (under 10x lens)

-
Product Name
Galectin-3 antibody
- Documents
-
Description
Galectin-3 Rabbit Polyclonal antibody. Positive IF detected in MCF-7 cells. Positive IHC detected in human thyroid cancer tissue, human colon cancer tissue. Positive IP detected in MCF-7 cells. Positive WB detected in NIH/3T3 cells, HeLa cells, human heart tissue, MCF7 cells, rat colon tissue. Observed molecular weight by Western-blot: 31 kDa
-
Tested applications
ELISA, IP, IHC, WB, IF
-
Species reactivity
Human,Mouse,Rat; other species not tested.
-
Alternative names
35 kDa lectin antibody; CBP 35 antibody; CBP35 antibody; Gal 3 antibody; GAL3 antibody; Galactose specific lectin 3 antibody; Galactoside binding protein antibody; GALBP antibody; Galectin 3 antibody; Galectin-3 antibody; GALIG antibody; IgE binding protein antibody; L 31 antibody; Laminin binding protein antibody; Lectin L 29 antibody; LGALS2 antibody; LGALS3 antibody; Mac 2 antigen antibody; MAC2 antibody
-
Isotype
Rabbit IgG
-
Preparation
This antibody was obtained by immunization of Galectin-3 recombinant protein (Accession Number: NM_002306). Purification method: Antigen affinity purified.
-
Clonality
Polyclonal
-
Formulation
PBS with 0.02% sodium azide and 50% glycerol pH 7.3.
-
Storage instructions
Store at -20℃. DO NOT ALIQUOT
-
Applications
Recommended Dilution:
WB: 1:200-1:2000
IP: 1:200-1:2000
IHC: 1:20-1:200
IF: 1:10-1:100
-
Validations

NIH/3T3 cells were subjected to SDS PAGE followed by western blot with Catalog No:110840(Galectin 3 Antibody) at dilution of 1:600
Immunohistochemical of paraffin-embedded human thyroid cancer using Catalog No:110840(Galectin 3 antibody) at dilution of 1:50 (under 10x lens)

Immunohistochemical of paraffin-embedded human thyroid cancer using Catalog No:110840(Galectin 3 antibody) at dilution of 1:50 (under 40x lens)

IP Result of anti-Galectin 3 (IP:Catalog No:110840, 3ug; Detection:Catalog No:110840 1:500) with MCF-7 cells lysate 1600ug.

Immunofluorescent analysis of MCF-7 cells using Catalog No:110840(Galectin 3 Antibody) at dilution of 1:25 and Alexa Fluor 488-congugated AffiniPure Goat Anti-Rabbit IgG(H+L)
-
Background
Galectins are a family of animal lectins defined by shared characteristic amino-acid sequences and affinity for β-galactose-containing oligosac-charides (PMID: 8063692). Galectin-3 contains one carbohydrate recognition domain (CRD) and a proline- and glycine-rich N-terminal domain through which is able to form oligomers. Galectin-3 is widely expressed in many normal tissues and a variety of tumors. It is found intracellularly in nucleus and cytoplasm or secreted outside of cell, being present on the cell surface or in the extracellular space (PMID: 16478649). Galectin-3 is involved in various biological processes including cell growth, adhesion, differentiation, apoptosis, angiogenesis, immune response, neoplastic transformation and metastasis (PMID: 16478649; 14758078).
-
References
- Eadon MT, Hack BK, Alexander JJ, Xu C, Dolan ME, Cunningham PN. Cell cycle arrest in a model of colistin nephrotoxicity. Physiological genomics. 45(19):877-88. 2013.
- Zhang RN, Zheng B, Li LM, Zhang J, Zhang XH, Wen JK. Tongxinluo inhibits vascular inflammation and neointimal hyperplasia through blockade of the positive feedback loop between miR-155 and TNF-α. American journal of physiology. Heart and circulatory physiology. 307(4):H552-62. 2014.
Related Products / Services
Please note: All products are "FOR RESEARCH USE ONLY AND ARE NOT INTENDED FOR DIAGNOSTIC OR THERAPEUTIC USE"
